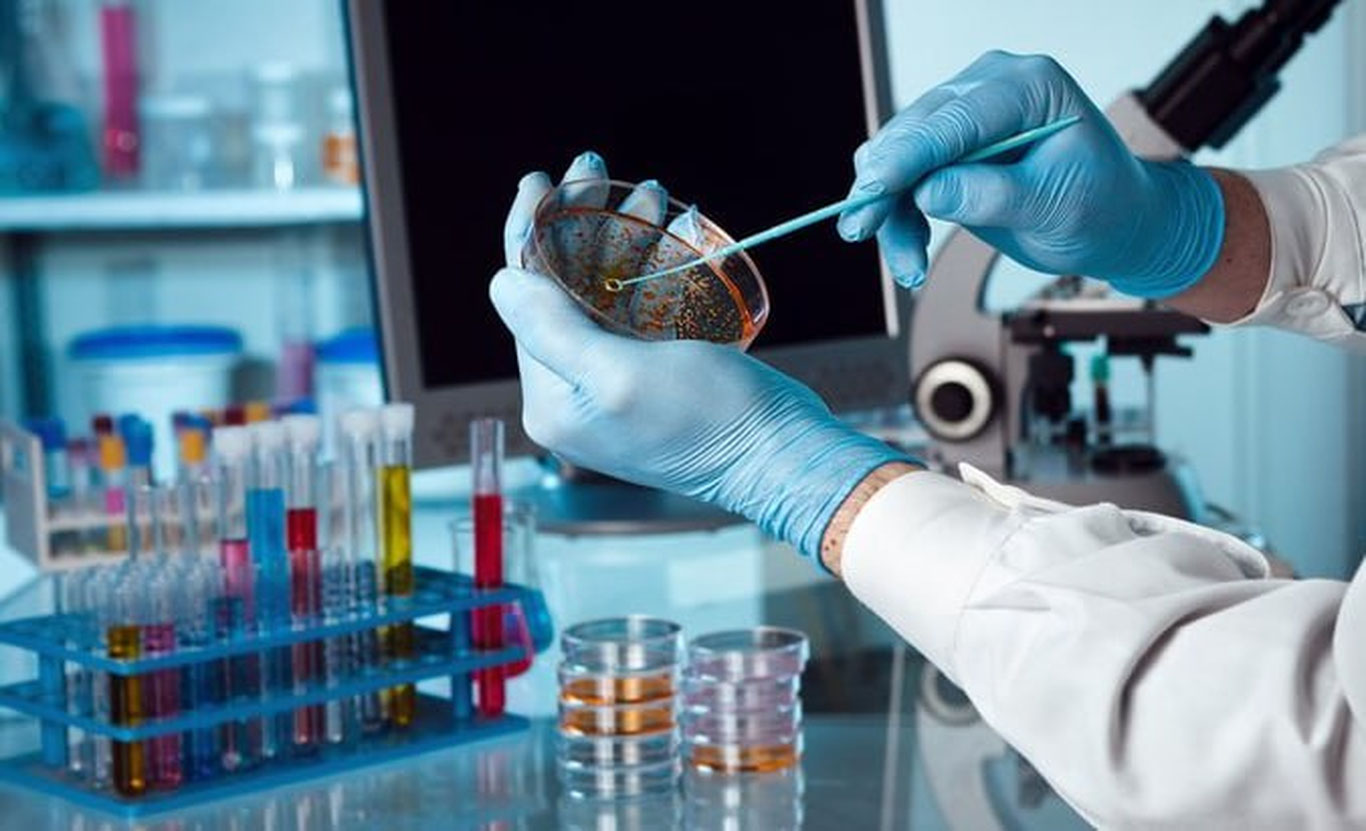

Қўқондаги уйда ҳам портлаш юз берди. Қурбон бор

Президент Шавкат Мирзиёев амалий ташриф билан АҚШга боради

Хилола Умарова вазир ўринбосари ва университет ректори лавозимига тайинланди

Рамазон ойидаги хайрия тадбирларига 1 триллион сўм ажратилади

Макрон Навалний вафотининг икки йиллиги муносабати билан баёнот берди